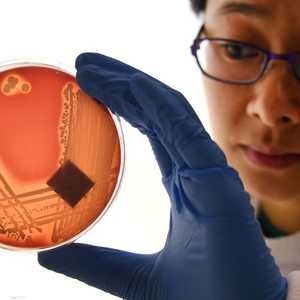
التجربة أجريت في المختبر

اثنان في واحد.. علماء يطورون لقاحا ضد كورونا والإنفلونزا
15:33 - 10 أكتوبر 2020
يعكف علماء في هونغ كونغ هذه الأيام على تطوير لقاح لمكافحة فيروس كورونا والإنفلونزا في آن واحد، خصوصا أن المرضين يصيبان نفس الأعضاء في الجسم ويتشابهان في الأعراض.
ويستهدف اللقاح الجديد كوفيد-19 والإنفلونزا معا، ويمكن أن يتم تناوله من خلال الرش في الأنف بدلا من الحقن بالإبر، ويوفر حماية من المرضين في آن واحد.
ومن المقرر أن يدخل اللقاح الجديد التجارب في هونغ كونغ في نوفمبر المقبل، ولن يكون اللقاح بحاجة للحصول على موافقة الجهات التنظيمية لعدة أشهر من أجل البدء في استخدامه إذا ما ثبتت نجاعته.
وقال يوين كووك يونغ، رئيس قسم الأمراض المعدية في قسم الأحياء الدقيقة بجامعة هونغ كونغ، والذي يشارك في الدراسة، إن المرحلة الأولى من التجارب ستبدأ في هونغ كونغ، وسيتم تسجيل حوالي 100 شخص بالغ لإتمامها.
وأضاف يوين في تصريحات لوكالة بلومبيرغ الأميركية: "فكرتنا هي أننا نريد الحماية من الإنفلونزا وكوفيد-19 في نفس الوقت".
ويستخدم اللقاح الجديد فيروس إنفلونزا ضعيف ينمو فقط في مجرى الهواء العلوي. ولا يمكن للفيروس الضعيف التكاثر، وقد تمت هندسته وراثيا ليشمل بروتين فيروس كورونا.
وإذا نجح اللقاح الجديد، فسيؤدي إلى استجابة مناعية ضد فيروس كورونا، إذ يجب أن ينتج جهاز المناعة أجساما مضادة معادلة لهذا البروتين المرتفع، مما يمنع الفيروس الحقيقي من التكاثر.
ويعمل اللقاح الجديد على حث جهاز المناعة على توليد أجسام مضادة تستجيب لفيروس الإنفلونزا الذي تم استخدامه في اللقاح. ومع ذلك، قد تظل فيروسات الإنفلونزا الأخرى معدية.
وقال يوين: "لقد ظهر أن اللقاح يعمل بطريقة جيدة في الحيوانات". وأضاف: "أعتقد أن لقاح الغشاء المخاطي فكرة رائعة"، مشيرًا إلى لقاحات الرش التي تستهدف الغشاء المخاطي للأنف.